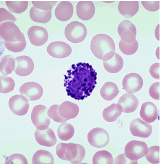
<p>What is the primary function of the leukocyte pictured?</p><p><br>A. Destroying cancerous or infected cells</p><p>B. Releases of histamine to start inflammation</p><p>C. Phagocytosis of foreign material</p><p>D. Turning off inflammation</p><p>E. Producing antibodies</p>

The Heart and Circulatory System Notes/Slides
1/203
Earn XP
Description and Tags
Plus Quiz 6 and Quiz 7
Name | Mastery | Learn | Test | Matching | Spaced | Call with Kai |
|---|
No analytics yet
Send a link to your students to track their progress
204 Terms

What is A
superior vena cava

What is B?
inferior vena cava

What is C?
coronary sinus

What is D?
right atrium

What is E?
tricuspid valve

What is F?
right ventricle

What is G?
pulmonary valve

What is H and I? (2)
pulmonary trunk and pulmonary arteries

(J) In pulmonary capillaries, blood loses _____________ and gains _________
co2 and o2

What is K?
pulmonary veins

What is L?
left atrium

What is M?
bicuspid valve

What is O
left ventricle

What is P
aortic valve

What is Q? (2)
aorta and systemic arteries

(R) In systemic capillaries, in systemic capillaries, blood loses __________ and gains ________
o2 and co2

What is the name of the structure in the image below
intercalated disc

What junctions do you find in high density at structure X?
gap junctions and desmosome

What is T?
left carotid artery

What is U?
left subclavian artery

What is V?
coronary vessel

What is W?
superior vena cava

What is X?
pulmonary trunk

What is Y?
brachiocephalic trunk

What is Z?
inferior vena cava
What is the primary pacemaker of the heart?
sinoatrial node
What term describes the ability of the heart to generate its own, regular contractions?
autorhythmic

What is A?
right atrium

What is B?
tricuspid valve

What is C?
left ventricle

What is D?
pulmonary valve

What is E?
left atrium
What is the primary epithelium of the trachea?
pseudostratified columnar epithelium
Which cartilage moves the vocal folds?
arytenoid cartilage
What structures in the conducting zone of the respiratory system help you to hold your breath?
the ventricular folds or false vocal cords which are located in the larynx
What is the function of Type II alveoli cells?
It produces alveolar fluid which contains a surfactant that helps prevent alveoli from collapsing
What is part of the Respiratory Zone of the respiratory system?
A. pleural cavity
B. primary bronchus
C. trachea
D. respiratory bronchiole
E. tertiary bronchiole
respiratory bronchiole

What is A?
superior lobe

What is B?
middle lobe

What is C?
inferior lobe

What is D?
cardiac notch

What is G?
oblique fissure
Which of the following are primary lymphatic organs? Select all that are correct.
A. lymphatic nodule
B. tonsils
C. spleen
D. thymus
E. red bone marrow
thymus and red bone marrow
Which of the follow leukocytes are helps induce inflammation?
A. leukocyte
B. basophil
C. neutrophil
D. macrophage
E. eosinophil
basophil
Blood is primarily composed of what?
plasma/water
What is the primary function of the leukocyte pictured?
A. Destroying cancerous or infected cells
B. Releases of histamine to start inflammation
C. Phagocytosis of foreign material
D. Turning off inflammation
E. Producing antibodies
B. Releases of histamine to start inflammation
Which of the following is not a function of the lymphatic system?
A. Transportation of lipids from the digestive system
B. Site of immune responses
C. Draining interstitial fluid
D. Transportation of hormones through the body
D. Transportation of hormones through the body
Select all of the organs/structures that are classified as Accessory Digestive Organs
A. Cecum
B. Stomach
C. Esophagus
D. Liver
E. Jejenum
F. Gall bladder
E. salivary gland
salivary gland, liver, and gall bladder
Which organ has three layers of smooth muscle in the muscularis layer?
A. stomach
B. small intestine
C. colon
D. esophagus
E. cecum
stomach
Which of the following organs would you find stratified squamous epithelia?
A. ileum
B. stomach
C. colon
D. esophagus
E. cecum
esophagus

What is W?
pancreatic duct

What is X?
gallbladder

What is Y?
hepatopancreatic ampulla

What is Z?
common bile duct
Which of the following organs does NOT secrete digestive enzymes?
A. liver
B. salivary glands
C. stomach
D. small intestine
E. pancreas
liver

What is the primary function of structure D in the image below?
controls the release of digesta into the duodenum

What is A?
cardiac sphincter

What is I?
fundus

What is H?
greater curvature

What is G?
antrum
In which organs would you find pilcae circulares
A. pharynx
B. stomach
C. esophagus
D. small intestine
E. large intestine
small intestine

What is A?
branch of the hepatic portal vein

What is B?
branch of hepatic artery

What is C?
bile duct

What is D?
central vein
Where are you most likely to find skeletal muscle in the gastrointestinal tract? Select all that apply.
A. pharynx
B. small intestine
C. anal sphincter
D. stomach
E. esophagus
pharynx, anal sphincter, and esophagus
Which of the following cell types secrete hydrochloric acid?
A. enteroendocrine cell
B. Pancreatic acini
C. gastric chief cell
D. absorptive cell
E. parietal cell
parietal cell

What is A?
aortic arch

What is B?
left common carotid artery

What is C?
left subclavian artery

What is D?
left pulmonary artery

What is E?
left pulmonary veins

What is F?
pulmonary trunk

What is G?
descending aorta

What is H?
inferior vena cava

What is I?
right pulmonary vein

What is J?
right pulmonary artery

What is K?
Brachiocephalic trunk

What is L?
superior vena cava

What is A?
left subclavian artery

What is B?
aortic arch

What is C?
pulmonary trunk

What is D?
left pulmonary vein

What is E?
left atrium

What is F?
bicuspid valve

What is G?
left ventricle

What is H?
aortic valve

What is I?
descending aorta

What is J?
papillary muscle

What is K?
chordae tendineae

What is L?
tricuspid valve

What is M?
pulmonary valve

What is N?
right atrium

What is O?
right pulmonary vein

What is P?
right pulmonary artery

What is Q?
superior vena cava

What is R?
brachiocephalic trunk

What is S?
left common carotid artery
Why is the muscle wall of the left ventricle thicker than the wall of the right ventricle?
the ventricle must pump to greater distances than the right ventricle, which only pumps to the lungs. So the difference in thickness is related to force needed
What is the purpose of heart valves?
to prevent backflow of blood in the heart and major arteries